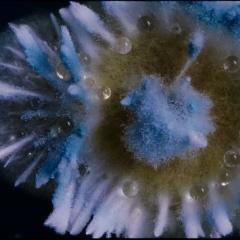

„Dainavoje" – vizionieriškas dokumentinis filmas (0)

Filmo peržiūroje dalyvaus ir filmo režisierė Aistė Žegulytė („Animus Animalis“), kuri sugrįžta su šešerius metus kurtu vizionierišku dokumentiniu filmu. Jame greta įspūdingo mikrogrybų kultūrų gyvenimo atsiveria ir žmogaus santykis su istorija bei nenuilstamos pastangos nuo neišvengiamo nykimo apsaugoti tai, kas brangu.
Filmo kūrėjai žiūrovus vedžioja meistrystės ir švelnaus humoro kupinais restauratorių kasdienybės koridoriais, pamaldumo ir pagarbos pripildytomis Valjadolido gatvėmis, pelėsio paveiktais, bet įtaigos nepraradusiais kinematografinės atminties vingiais. Žmonijos kūriniai neišvengiamai nyksta, tačiau žvelgiant pro mikroskopą blyksteli viltis. Nesustabdomas augimas tampa tylia, didinga pergale prieš mirtį. Geriausia lietuviška premjera Kino pavasaris festivalyje išrinktas filmas jau sulaukė ryškių kultūros lauko atstovų įvertinimų.
Rinkodaros ekspertė ir TV laidų vedėja Dovilė Filmanavičiūtė po premjeros svarstė apie filme keliamus klausimus: „Buvau beatiduodanti stebuklo titulą grybams, nes visą filmą su amžinybės (ne)buvimu bekovojantys žmonės vis tiek jų niekada nenugalės. Tik tuomet atėjo supratimas, kad niekas šiame filme nekovoja – labiau atiduoda save tam amžinybės ratui, kad jis nesustotų. Ir be mūsų, deja“, – dalijosi ji.
Režisierė Giedrė Beinoriūtė filmą vadina užburiančia kelione: „Jei reikėtų rinkti kūrybiškiausią pastarųjų metų filmą, savo balsą, be abejonės, atiduočiau „Dulkėms, kaulams ir stebuklams“. Suderinti tai, kas nesuderinama, sugretinti tai, kas nesugretinama, į vieną apskritimą sutalpinti ir grybus, ir karstus, ir velykinę procesiją Valjadolide – reikia ypatingo talento“, – teigė ji.
Kino kritikė Rūta Oginskaitė savo apžvalgoje pabrėžia, kad filmas veikia tarsi hipnozės seansas, o jo prasmės „auga ir dauginasi kaip ekrano grybų gėlynai“. Žiūrovai apie filmą aktyviai diskutuoja ir platformoje Letterboxd, kur jis apibūdinamas kaip jautrus, vizualiai stiprus ir į pasąmonę įsiskverbiantis kūrinys.
Bilietai: https://kinasdainava.lt/filmai/dulkes-kaulai-ir-stebuklai

Komentarai
Palikite savo komentarą